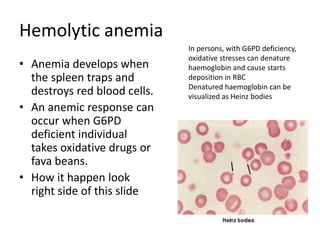
Hemolytic anemia
• Anemia develops when
the spleen traps and
destroys red blood cells.
• An anemic response can
occur when G6PD
deficient individual
takes oxidative drugs or
fava beans.
• How it happen look
right side of this slide
In persons, with G6PD deficiency,
oxidative stresses can denature
haemoglobin and cause starts
deposition in RBC
Denatured haemoglobin can be
visualized as Heinz bodies

Glucose-6-phosphate dehydrogenase deficiency (G6PD deficiency) is an inherited metabolic disorder that leads to hemolytic anemia due to the inability to detoxify reactive oxygen species, affecting over 400 million people globally. The condition is caused by mutations in the G6PD gene located on the X chromosome, with males being more severely affected due to having only one X chromosome. Diagnosis involves blood tests, and treatment may include blood transfusions, antioxidants, and avoidance of triggers such as fava beans and certain medications.